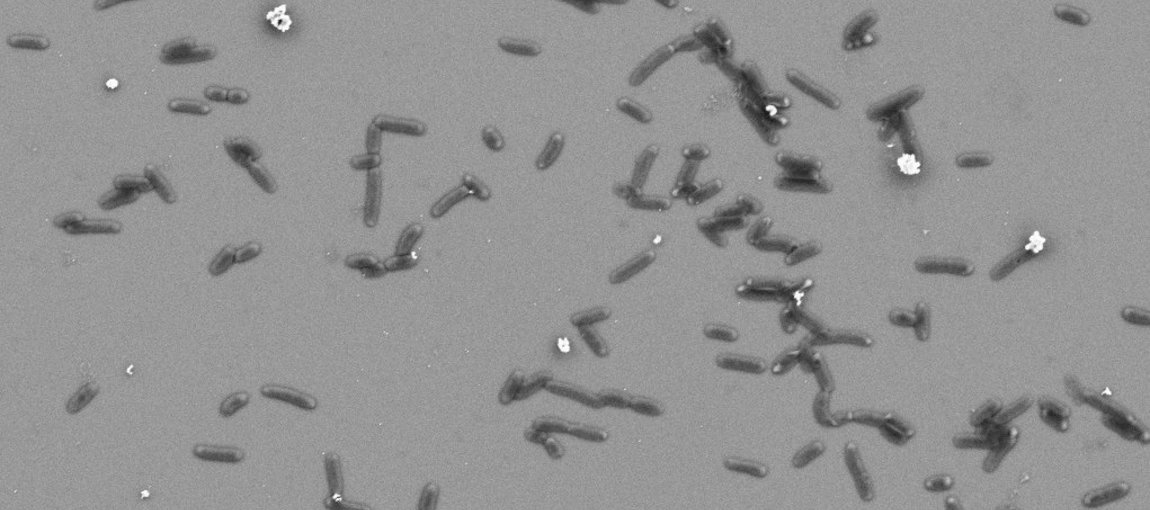

Biointerfaces
Biointerfaces play a major role in biocompatibility, drug delivery, biofilm formation,healing processes or cancer research. The characterization of the elementary reaction steps is accessible by XPS, especially due to its surface sensitivity. But drying of biomaterials also change the processes signifcantly. Thus NAP-XPS ist perfectly suited to contribute to this field of research.
Your web browser is deprecated
This could effect the presentation and some functions of our website.